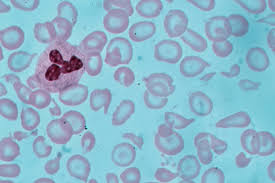
blood

Book Doctors, Diagnostics & Healthcare Services Near You
Powered by 24x7 Health – Your trusted healthcare platform

Instant Video Consultation
Consult experienced and verified doctors online through secure video calls. Get medical advice, prescriptions and follow-ups within minutes from your home.

Find Doctors Near You
Search and book appointments with verified doctors, specialists and physicians near your location. Consult online or visit clinics with confirmed bookings.

Find Clinics Near You
Discover top-rated clinics and hospitals near you for consultations, treatments and follow-up care with trusted healthcare providers.

Diagnostics
Book diagnostic tests including blood tests, scans, MRI, X-ray and pathology services from trusted labs near your location.